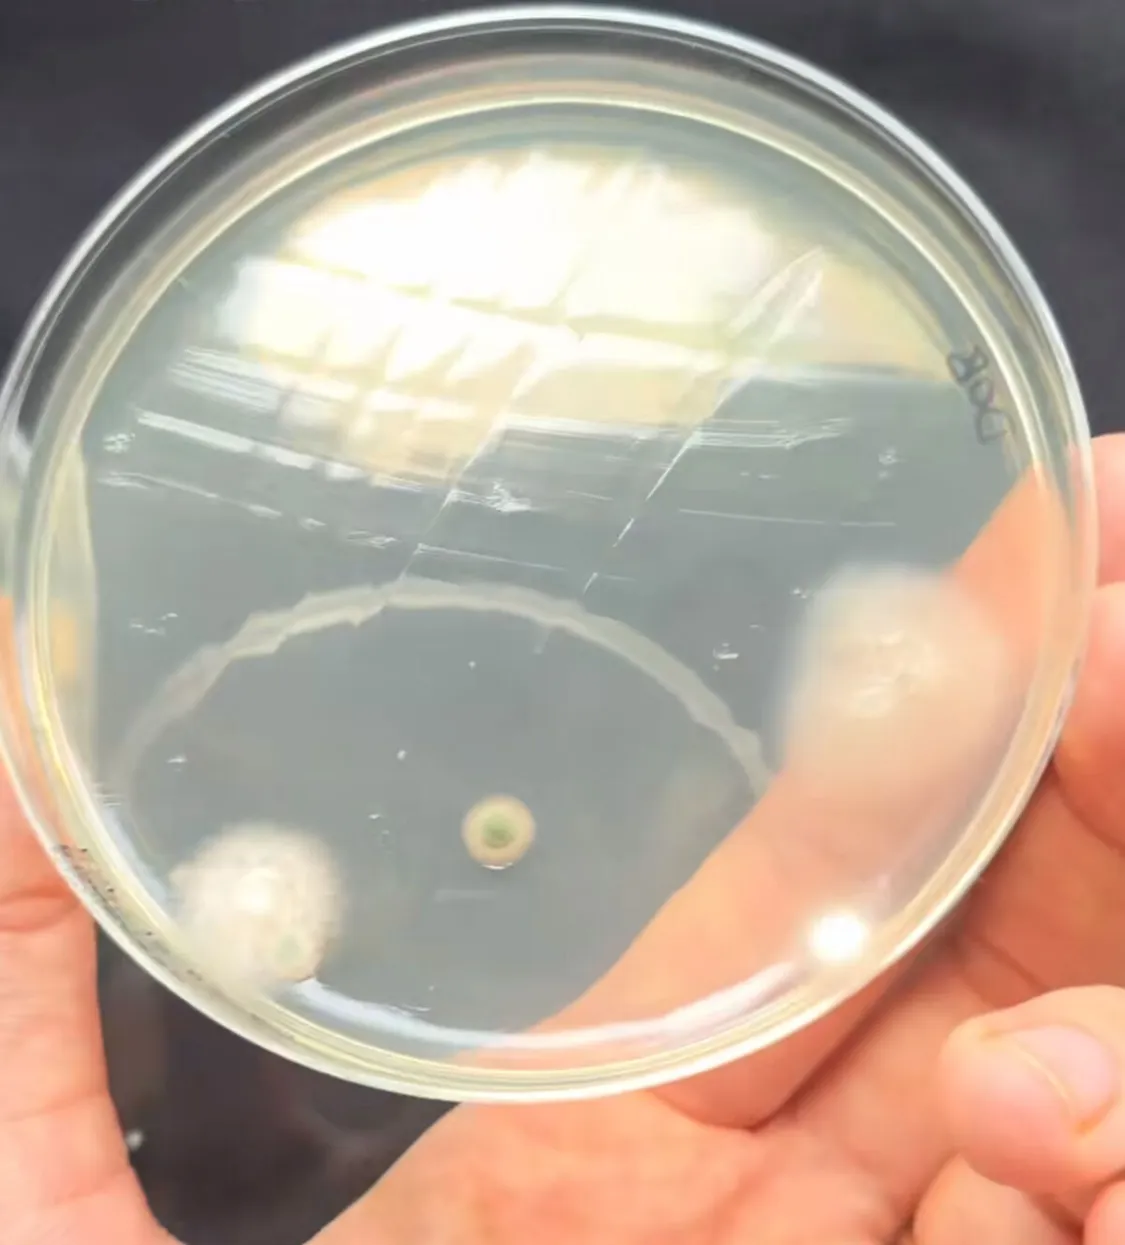
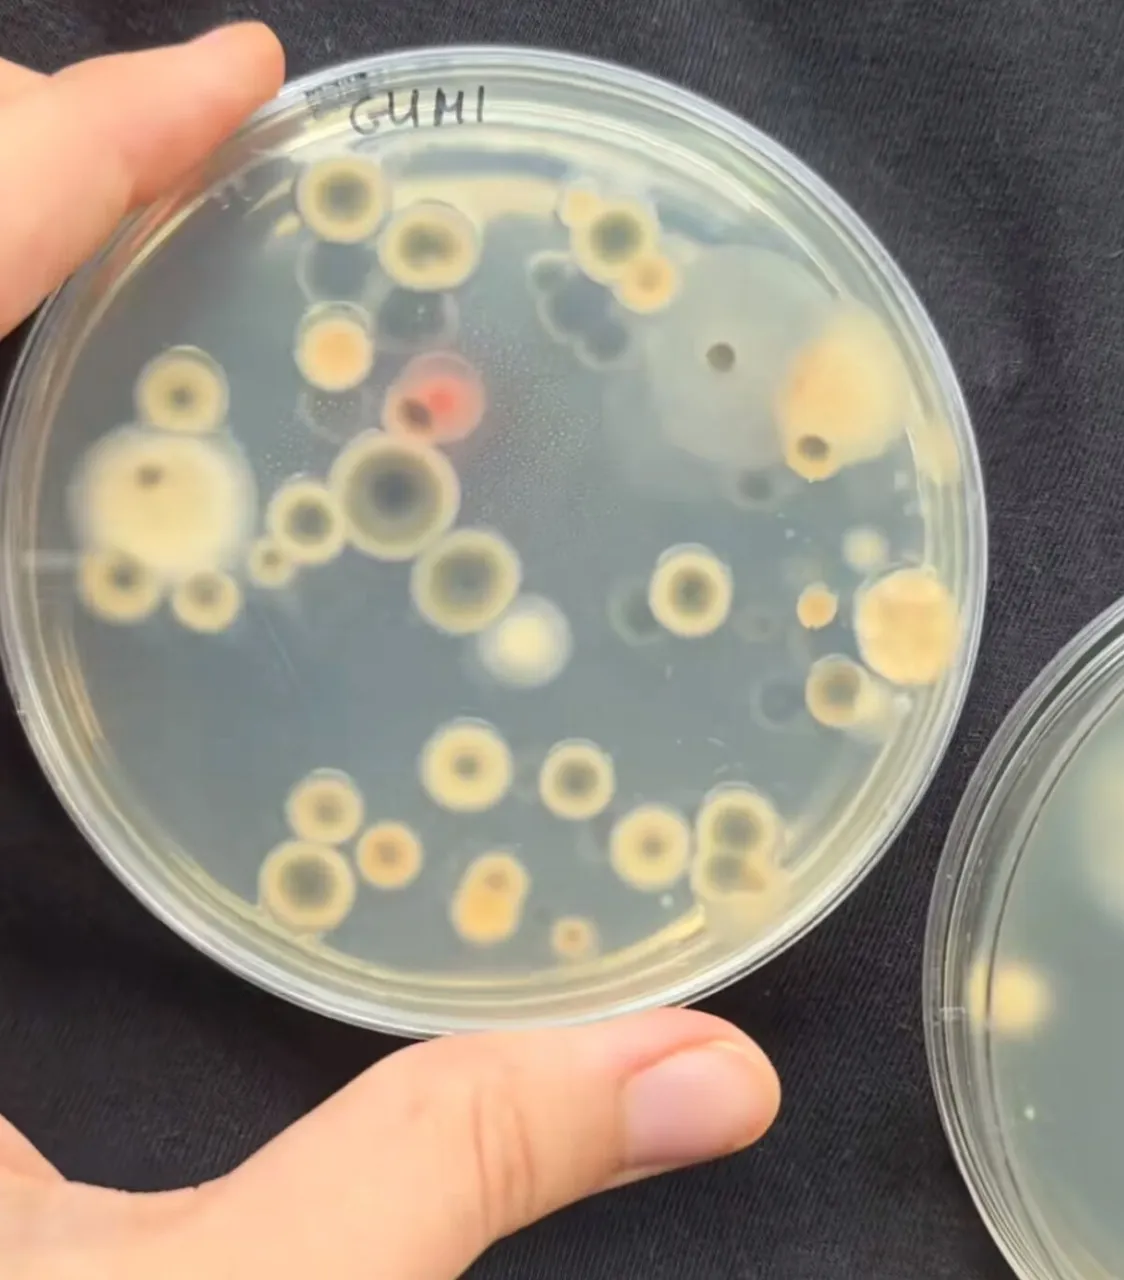

Itt a nagy mosógépteszt: nem hiszed el, hogy mik élnek benne!
Sűrűn használjuk, de nem biztos, hogy megfelelően takarítjuk. Gyuris Rita megmutatta, hogy miket rejtenek a mosógép rejtett zugai.
Gyuris Rita, a TikTok kedvenc növényorvosa folyamatosan figyelemmel kíséri a követői kívánságait és teszteli, amit kérnek tőle. Többek között bemutatta már, hogy milyen gomba- és baktériumtelepek élnek egyes élelmiszereken, használati tárgyakon, vagy éppen az emberi bőrön. Nemrégiben a mosógépet vette górcső alá. Szinte minden háztartásban megtalálható és rendszeres használatban van, de tudjuk, hogy mik élnek az eldugott részeiben? Most kiderül!

Íme a nagy mosógép-teszt!
„Közkívánatra jöjjön a nagy mosógép-teszt!” – kezdte TikTok videójában Gyuris Rita, aki mintát vett a mosógép gumis részéből és a dobból is.
A dob részről próbáltam alaposan, körbe-körbe mindenhonnan mintát venni
– ismertette Rita, majd a mintavevő pálcát hozzádörzsölte a speciális táptalajhoz, úgynevezett agar lemezhez, hogy kitenyéssze azokat.
Az első agar lemezre a dob mintáit helyeztem rá, amin összesen három-négy gombatelep jelent meg. A gumis részből vett minta sokkal durvább. Szemmel láthatóan több gombatelep nőtt fel. Szemmel nem látható, hogy egy-egy gombatelep alatt van baktériumkolónia is; mivel együtt növekedtek, ránőtt a gombatelep
– állapította meg Rita, hozzátéve: „Tanulság, hogy érdemes a gumis részt is áttörölni, kitakarítani néha.”
Rita a kilincset is tesztelte
Gyuris Rita korábban bemutatta, hogy mennyi baktérium és gombatelep található a bejárati ajtó kilincsén. A mintavétel után letakarította a kilincset és a tiszta felületről is mintát vett; a különbség megdöbbentő volt.
„Már az első napra számos baktériumkolónia és gombatelep nőtt fel. Alakjukból, színükből, méretükből kifolyólag is más-más baktériumok és gombák. Az idő előrehaladtával ezek a mikroorganizmusok szaporodnak, tehát a telepek és a kolóniák növekedni kezdenek. A tisztított kilincsen egyetlen egy gombatelep jelent meg. A teszt szépen megmutatja, hogy mennyire fontos a takarítás és hogy milyen sok baktériumot vihetünk be egy mozdulattal a lakásba. Éppen ezért fontos, hogy rendszeresen tisztítsuk meg a kilincseket. Minden ötödik magyar soha, vagy csak a beköltözéskor tisztította meg a bejárati ajtó kilincsét. Az embereknek pedig mindössze negyede törli le a kilincseket és a kapcsolókat az otthonában” - összegezte a növényorvos.






